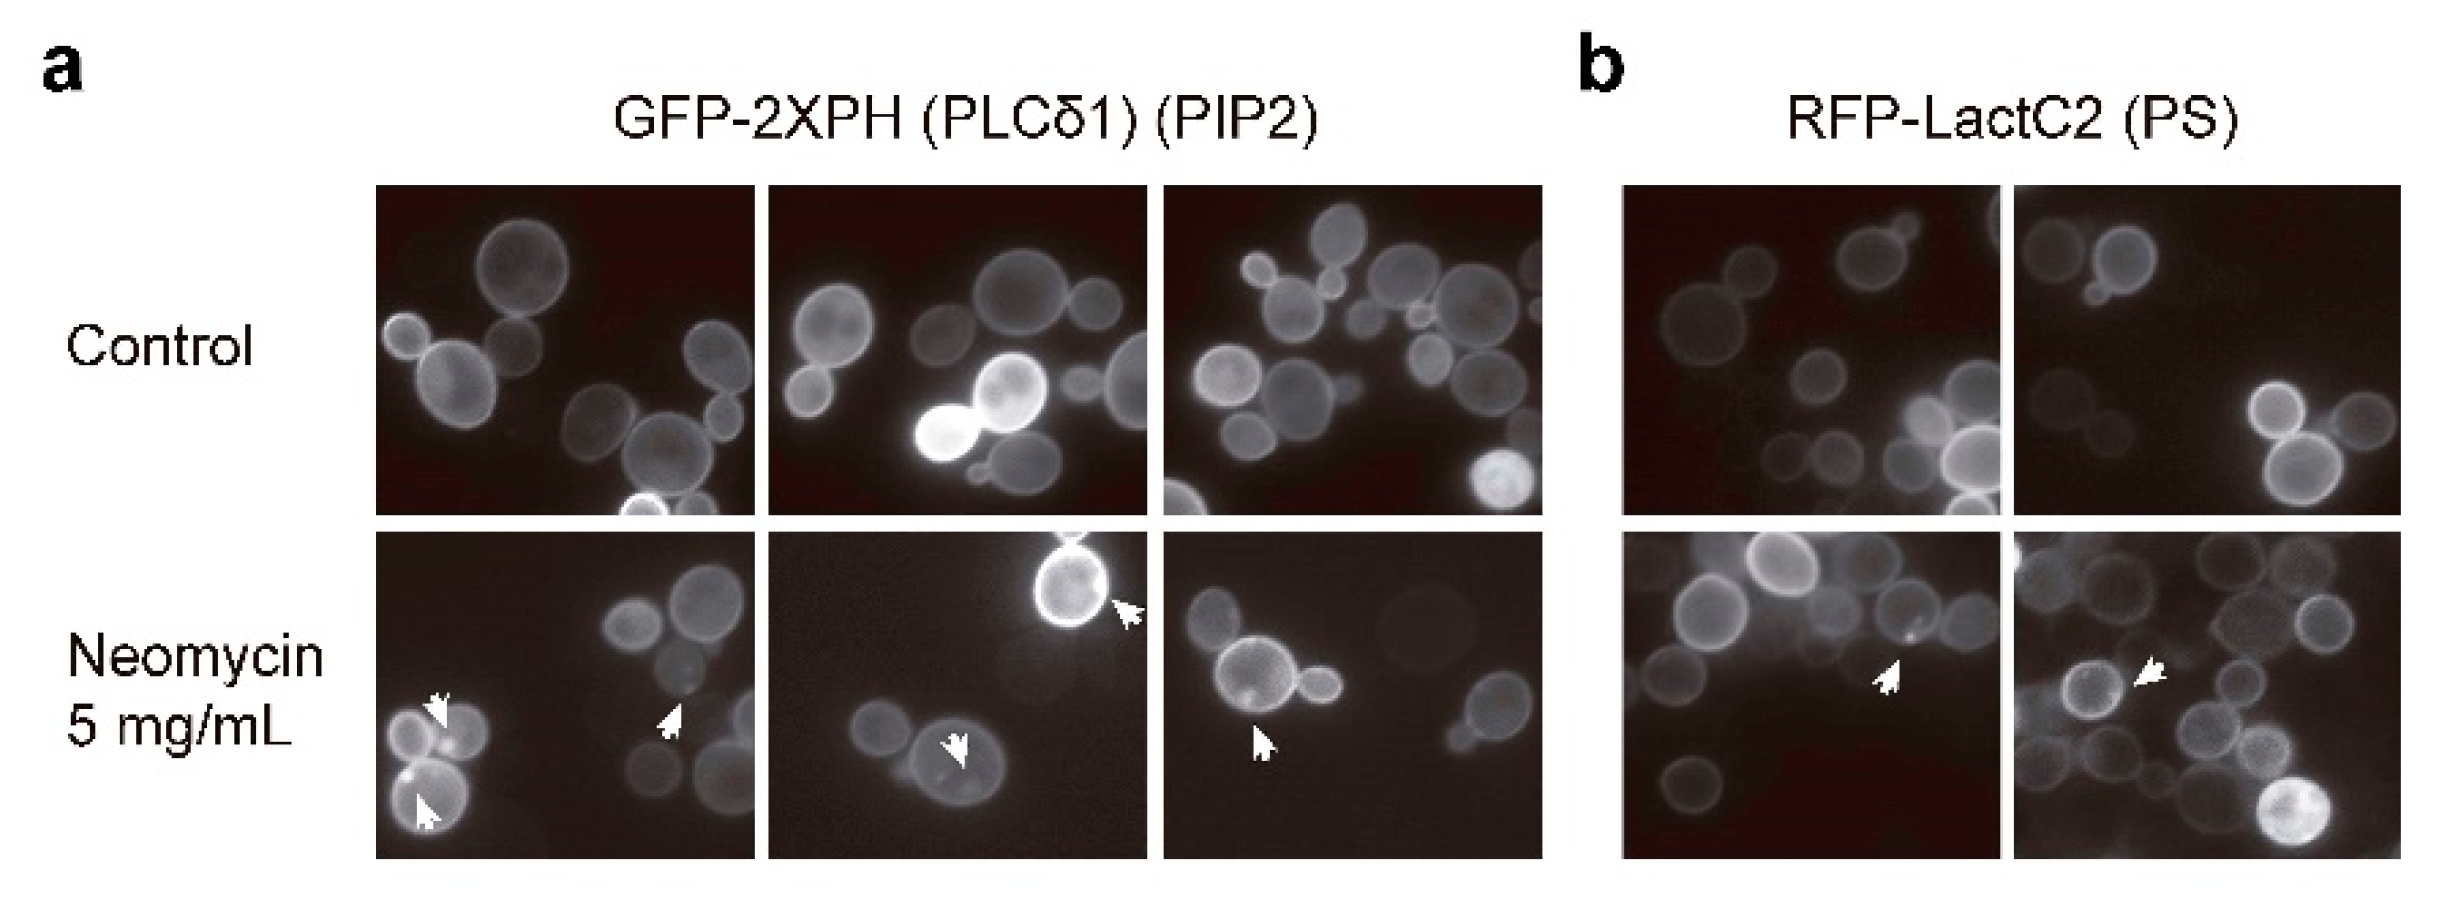
Ijms 23 11034 g005a

Neomycin Interferes with Phosphatidylinositol-4,5-Bisphosphate at the Yeast Plasma Membrane and Activates the Cell Wall Integrity Pathway
Abstract
1. Introduction
2. Results
2.1. Genomic Integration of IPAC Drives Higher CWI Pathway Activation Than Its Expression from a Centromeric Plasmid
2.2. Identification of Novel CWI Pathway-Activating Compounds by Using the IPAC
2.3. Neomycin, but Not Other Aminoglucosides, Activates the CWI Pathway
2.4. Analysis of Signaling Triggered by Neomycin through the Cell Wall Integrity Pathway
2.5. Neomycin Reduces PIP2 Availability at the Yeast Plasma Membrane
2.6. TORC2-Dependent Ypk1 Phosphorylation Is Reduced upon Neomycin Exposure
2.7. Transcriptional Profile Induced by Neomycin
3. Discussion
4. Materials and Methods
4.1. Strains and Growth Conditions
4.2. DNA Manipulation and Plasmids
4.3. Halo Sensitivity Assays
4.4. Multiwell Plate Sensitivity Assay
4.5. Yeast Drop Dilution Growth Assay
4.6. Preparation of Yeast Extracts and Immunoblotting Analysis
4.7. β-Galactosidase Activity Assay
4.8. Fluorescence Microscopy
4.9. Transcriptional Analysis by DNA Microarray Technology
4.10. Reverse Transcription Quantitative Real-Time PCR (RT-qPCR)
Supplementary Materials
Author Contributions
Funding
Institutional Review Board Statement
Informed Consent Statement
Data Availability Statement
Acknowledgments
Conflicts of Interest
References
- Morrison, D.K. MAP Kinase Pathways. Cold Spring Harb. Perspect. Biol. 2012, 4, a011254. [Google Scholar] [CrossRef] [PubMed]
- Chen, R.E.; Thorner, J. Function and Regulation in MAPK Signaling Pathways. Biochim. Biophys. Acta 2007, 1773, 1311–1340. [Google Scholar] [CrossRef] [PubMed]
- Levin, D.E. Regulation of Cell Wall Biogenesis in Saccharomyces cerevisiae: The Cell Wall Integrity Signaling Pathway. Genetics 2011, 189, 1145–1175. [Google Scholar] [CrossRef] [PubMed]
- Jiménez-Gutiérrez, E.; Alegría-Carrasco, E.; Sellers-Moya, Á.; Molina, M.; Martín, H. Not Just the Wall: The Other Ways to Turn the Yeast CWI Pathway On. Int. Microbiol. 2020, 23, 107–119. [Google Scholar] [CrossRef]
- Sanz, A.; García, R.; Rodríguez-Peña, J.; Arroyo, J. The CWI Pathway: Regulation of the Transcriptional Adaptive Response to Cell Wall Stress in Yeast. J. Fungi 2017, 4, 1. [Google Scholar] [CrossRef]
- Madden, K.; Sheu, Y.J.; Baetz, K.; Andrews, B.; Snyder, M. SBF Cell Cycle Regulator as a Target of the Yeast PKC-MAP Kinase Pathway. Science 1997, 275, 1781–1784. [Google Scholar] [CrossRef]
- Kim, K.Y.; Levin, D.E. Transcriptional Reporters for Genes Activated by Cell Wall Stress through a Non-Catalytic Mechanism Involving Mpk1 and SBF. Yeast 2010, 27, 541–548. [Google Scholar] [CrossRef]
- Inagaki, M.; Schmelzle, T.; Yamaguchi, K.; Irie, K.; Hall, M.N.; Matsumoto, K. PDK1 Homologs Activate the Pkc1–Mitogen-Activated Protein Kinase Pathway in Yeast. Mol. Cell. Biol. 1999, 19, 8344–8352. [Google Scholar] [CrossRef]
- Nomura, W.; Inoue, Y. Methylglyoxal Activates the Target of Rapamycin Complex 2-Protein Kinase C Signaling Pathway in Saccharomyces cerevisiae. Mol. Cell. Biol. 2015, 35, 1269–1280. [Google Scholar] [CrossRef]
- Niles, B.J.; Mogri, H.; Hill, A.; Vlahakis, A.; Powers, T. Plasma Membrane Recruitment and Activation of the AGC Kinase Ypk1 Is Mediated by Target of Rapamycin Complex 2 (TORC2) and Its Effector Proteins Slm1 and Slm2. Proc. Natl. Acad. Sci. USA 2012, 109, 1536–1541. [Google Scholar] [CrossRef]
- Gaubitz, C.; Prouteau, M.; Kusmider, B.; Loewith, R. TORC2 Structure and Function. Trends Biochem. Sci. 2016, 41, 532–545. [Google Scholar] [CrossRef] [PubMed]
- Roelants, F.M.; Torrance, P.D.; Bezman, N.; Thorner, J. Pkh1 and Pkh2 Differentially Phosphorylate and Activate Ypk1 and Ykr2 and Define Protein Kinase Modules Required for Maintenance of Cell Wall Integrity. Mol. Biol. Cell 2002, 13, 3005–3028. [Google Scholar] [CrossRef] [PubMed]
- Roelants, F.M.; Torrance, P.D.; Thorner, J. Differential Roles of PDK1- and PDK2-Phosphorylation Sites in the Yeast AGC Kinases Ypk1, Pkc1 and Sch9. Microbiology 2004, 150, 3289–3304. [Google Scholar] [CrossRef] [PubMed]
- Eltschinger, S.; Loewith, R. TOR Complexes and the Maintenance of Cellular Homeostasis. Trends Cell Biol. 2016, 26, 148–159. [Google Scholar] [CrossRef] [PubMed]
- Berchtold, D.; Piccolis, M.; Chiaruttini, N.; Riezman, I.; Riezman, H.; Roux, A.; Walther, T.C.; Loewith, R. Plasma Membrane Stress Induces Relocalization of Slm Proteins and Activation of TORC2 to Promote Sphingolipid Synthesis. Nat. Publ. Gr. 2012, 14, 542–547. [Google Scholar] [CrossRef] [PubMed]
- Roelants, F.; Leskoske, K.; Martinez Marshall, M.N.; Locke, M.; Thorner, J. The TORC2-Dependent Signaling Network in the Yeast Saccharomyces cerevisiae. Biomolecules 2017, 7, 66. [Google Scholar] [CrossRef]
- Guo, Y.; Pan, W.; Liu, S.; Shen, Z.; Xu, Y.; Hu, L. ERK/MAPK Signalling Pathway and Tumorigenesis (Review). Exp. Ther. Med. 2020, 19, 1997–2007. [Google Scholar] [CrossRef]
- González-Rubio, G.; Fernández-Acero, T.; Martín, H.; Molina, M. Mitogen-Activated Protein Kinase Phosphatases (MKPs) in Fungal Signaling: Conservation, Function, and Regulation. Int. J. Mol. Sci. 2019, 20, 1709. [Google Scholar] [CrossRef]
- Sharifian, H.; Lampert, F.; Stojanovski, K.; Regot, S.; Vaga, S.; Buser, R.; Lee, S.S.; Koeppl, H.; Posas, F.; Pelet, S.; et al. Parallel Feedback Loops Control the Basal Activity of the HOG MAPK Signaling Cascade. Integr. Biol. 2015, 7, 412–422. [Google Scholar] [CrossRef]
- García, R.; Sanz, A.B.; Rodríguez-Peña, J.M.; Nombela, C.; Arroyo, J. Rlm1 Mediates Positive Autoregulatory Transcriptional Feedback That Is Essential for Slt2-Dependent Gene Expression. J. Cell Sci. 2016, 129, 1649–1660. [Google Scholar] [CrossRef]
- Brandman, O.; Meyer, T. Feedback Loops Shape Cellular Signals in Space and Time. Science 2008, 322, 390–395. [Google Scholar] [CrossRef] [PubMed]
- Watanabe, Y.; Irie, K.; Matsumoto, K. Yeast RLM1 Encodes a Serum Response Factor-like Protein That May Function Downstream of the Mpk1 (Slt2) Mitogen-Activated Protein Kinase Pathway. Mol. Cell. Biol. 1995, 15, 5740–5749. [Google Scholar] [CrossRef] [PubMed]
- García, R.; Bermejo, C.; Grau, C.; Pérez, R.; Rodríguez-Peña, J.M.; Francois, J.; Nombela, C.; Arroyo, J. The Global Transcriptional Response to Transient Cell Wall Damage in Saccharomyces cerevisiae and Its Regulation by the Cell Integrity Signaling Pathway. J. Biol. Chem. 2004, 279, 15183–15195. [Google Scholar] [CrossRef] [PubMed]
- Jiménez-Gutiérrez, E.; Alegría-Carrasco, E.; Alonso-Rodríguez, E.; Fernández-Acero, T.; Molina, M.; Martín, H. Rewiring the Yeast Cell Wall Integrity (CWI) Pathway through a Synthetic Positive Feedback Circuit Unveils a Novel Role for the MAPKKK Ssk2 in CWI Pathway Activation. FEBS J. 2020, 287, 4881–4901. [Google Scholar] [CrossRef] [PubMed]
- García, R.; Rodríguez-Peña, J.M.; Bermejo, C.; Nombela, C.; Arroyo, J. The High Osmotic Response and Cell Wall Integrity Pathways Cooperate to Regulate Transcriptional Responses to Zymolyase-Induced Cell Wall Stress in Saccharomyces cerevisiae. J. Biol. Chem. 2009, 284, 10901–10911. [Google Scholar] [CrossRef]
- Marín, M.J.; Flández, M.; Bermejo, C.; Arroyo, J.; Martín, H.; Molina, M. Different Modulation of the Outputs of Yeast MAPK-Mediated Pathways by Distinct Stimuli and Isoforms of the Dual-Specificity Phosphatase Msg5. Mol. Genet. Genomics 2009, 281, 345–359. [Google Scholar] [CrossRef]
- Schneider-Poetsch, T.; Ju, J.; Eyler, D.E.; Dang, Y.; Bhat, S.; Merrick, W.C.; Green, R.; Shen, B.; Liu, J.O. Inhibition of Eukaryotic Translation Elongation by Cycloheximide and Lactimidomycin. Nat. Chem. Biol. 2010, 6, 209–217. [Google Scholar] [CrossRef]
- Martin, H.; Shales, M.; Fernandez-Piñar, P.; Wei, P.; Molina, M.; Fiedler, D.; Shokat, K.M.; Beltrao, P.; Lim, W.; Krogan, N.J. Differential Genetic Interactions of Yeast Stress Response MAPK Pathways. Mol. Syst. Biol. 2015, 11, 800. [Google Scholar] [CrossRef]
- Flández, M.; Cosano, I.C.; Nombela, C.; Martín, H.; Molina, M. Reciprocal Regulation between Slt2 MAPK and Isoforms of Msg5 Dual-Specificity Protein Phosphatase Modulates the Yeast Cell Integrity Pathway. J. Biol. Chem. 2004, 279, 11027–11034. [Google Scholar] [CrossRef]
- Tatjer, L.; Sacristán-Reviriego, A.; Casado, C.; González, A.; Rodríguez-Porrata, B.; Palacios, L.; Canadell, D.; Serra-Cardona, A.; Martín, H.; Molina, M.; et al. Wide-Ranging Effects of the Yeast Ptc1 Protein Phosphatase Acting Through the MAPK Kinase Mkk1. Genetics 2016, 202, 141–156. [Google Scholar] [CrossRef]
- Gabev, E.; Kasianowicz, J.; Abbott, T.; McLaughlin, S. Binding of Neomycin to Phosphatidylinositol 4,5-Biphosphate (PIP2). BBA Biomembr. 1989, 979, 105–112. [Google Scholar] [CrossRef]
- Schacht, J. Inhibition By Neomycin of Polyphosphoinositide Turnover in Subcellular Fractions of Guinea-Pig Cerebral Cortex in Vitro. J. Neurochem. 1976, 27, 1119–1124. [Google Scholar] [CrossRef] [PubMed]
- Hammond, G.R.V.; Dove, S.K.; Nicol, A.; Pinxteren, J.A.; Zicha, D.; Schiavo, G. Elimination of Plasma Membrane Phosphatidylinositol (4,5)-Bisphosphate Is Required for Exocytosis from Mast Cells. J. Cell Sci. 2006, 119, 2084–2094. [Google Scholar] [CrossRef]
- Fernández-Acero, T.; Rodríguez-Escudero, I.; Molina, M.; Cid, V.J. The Yeast Cell Wall Integrity Pathway Signals from Recycling Endosomes upon Elimination of Phosphatidylinositol (4,5)-Bisphosphate by Mammalian Phosphatidylinositol 3-Kinase. Cell. Signal. 2015, 27, 2272–2284. [Google Scholar] [CrossRef] [PubMed]
- Wang, C.; Du, X.; Jia, Q.; Zhang, H. Binding of PLCδ1PH-GFP to PtdIns(4,5)P2 Prevents Inhibition of Phospholipase C-Mediated Hydrolysis of PtdIns(4,5)P2 by Neomycin. Acta Pharmacol. Sin. 2005, 26, 1485–1491. [Google Scholar] [CrossRef]
- Coronas-Serna, J.M.; Fernández-Acero, T.; Molina, M.; Cid, V.J. A Humanized Yeast-Based Toolkit for Monitoring Phosphatidylinositol 3-Kinase Activity at Both Single Cell and Population Levels. Microb. Cell 2018, 5, 545–554. [Google Scholar] [CrossRef]
- Rodríguez-Escudero, I.; Roelants, F.M.; Thorner, J.; Nombela, C.; Molina, M.; Cid, V.J. Reconstitution of the Mammalian PI3K/PTEN/Akt Pathway in Yeast. Biochem. J. 2005, 390, 613–623. [Google Scholar] [CrossRef]
- Leskoske, K.L.; Roelants, F.M.; Martinez Marshall, M.N.; Hill, J.M.; Thorner, J. The Stress-Sensing TORC2 Complex Activates Yeast AGC-Family Protein Kinase Ypk1 at Multiple Novel Sites. Genetics 2017, 207, 179–195. [Google Scholar] [CrossRef]
- Komili, S.; Farny, N.G.; Roth, F.P.; Silver, P.A. Functional Specificity among Ribosomal Proteins Regulates Gene Expression. Cell 2007, 131, 557–571. [Google Scholar] [CrossRef]
- García, R.; Botet, J.; Rodríguez-peña, J.M.; Bermejo, C.; Ribas, J.C.; Revuelta, J.L.; Nombela, C.; Arroyo, J. Genomic Profiling of Fungal Cell Wall-Interfering Compounds: Identification of a Common Gene Signature. BMC Genomics 2015, 16, 1–20. [Google Scholar] [CrossRef]
- Yan, P.; Xu, D.; Ji, Y.; Yin, F.; Cui, J.; Su, R.; Wang, Y.; Zhu, Y.; Wei, S.; Lai, J. LiCl Pretreatment Ameliorates Adolescent Methamphetamine Exposure-induced long-term alterations in behavior and hippocampal ultrastructure in adulthood in mice. Int. J. Neuropsychopharmacol. 2019, 22, 303–316. [Google Scholar] [CrossRef] [PubMed]
- Ito, H.; Fukuda, Y.; Murata, K.; Kimura, A. Transformation of intact yeast cells treated with alkali cations. J Bacteriol. 1983, 153, 163–168. [Google Scholar] [CrossRef] [PubMed]
- Feigl, G.; Lehotai, N.; Molnár, Á.; Ördög, A.; Rodríguez-Ruiz, M.; Palma, J.M.; Corpas, F.J.; Erdei, L.; Kolbert, Z. Zinc induces distinct changes in the metabolism of reactive oxygen and nitrogen species (ROS and RNS) in the roots of two Brassica species with different sensitivity to zinc stress. Ann. Bot. 2015, 116, 613–625. [Google Scholar] [CrossRef]
- Kubo, I.; Lee, S.H.; Ha, T.J. Effect of EDTA alone and in combination with polygodial on the growth of Saccharomyces cerevisiae. J. Agric. Food Chem. 2005, 53, 1818–1822. [Google Scholar] [CrossRef] [PubMed]
- Vardanyan, R.S.; Hruby, V.J. Chapter 32: Antibiotics. In Synthesis of Essential Drugs, 1st ed.; Elsevier: Amsterdam, The Netherlands, 2006; pp. 477–478. [Google Scholar]
- Wang, B.M.; Weiner, N.D.; Ganesan, M.G.; Schacht, J. Interaction of Calcium and Neomycin with Anionic Phospholipid-Lecithin Liposomes. A Differential Scanning Calorimetry Study. Biochem. Pharmacol. 1984, 33, 3787–3791. [Google Scholar] [CrossRef]
- Arbuzova, A.; Martushova, K.; Hangyás-Mihályné, G.; Morris, A.J.; Ozaki, S.; Prestwich, G.D.; McLaughlin, S. Fluorescently Labeled Neomycin as a Probe of Phosphatidylinositol-4,5-Bisphosphate in Membranes. Biochim. Biophys. Acta Biomembr. 2000, 1464, 35–48. [Google Scholar] [CrossRef]
- Seo, J.B.; Jung, S.R.; Huang, W.; Zhang, Q.; Koh, D.S. Charge Shielding of PIP2 by Cations Regulates Enzyme Activity of Phospholipase C. PLoS ONE 2015, 10, e0144432. [Google Scholar] [CrossRef] [PubMed]
- Riggi, M.; Niewola-Staszkowska, K.; Chiaruttini, N.; Colom, A.; Kusmider, B.; Mercier, V.; Soleimanpour, S.; Stahl, M.; Matile, S.; Roux, A.; et al. Decrease in Plasma Membrane Tension Triggers PtdIns(4,5)P 2 Phase Separation to Inactivate TORC2. Nat. Cell Biol. 2018, 20, 1043–1051. [Google Scholar] [CrossRef]
- Marshall, M.N.M.; Emmerstorfer-Augustin, A.; Leskoske, K.L.; Zhang, L.H.; Li, B.; Thorner, J. Analysis of the Roles of Phosphatidylinositol-4,5-Bisphosphate and Individual Subunits in Assembly, Localization, and Function of Saccharomyces Cerevisiae Target of Rapamycin Complex 2. Mol. Biol. Cell 2019, 30, 1555–1574. [Google Scholar] [CrossRef]
- Huang, K.; Wang, X.; Liu, Y.; Zhao, Y. CRAC Channel Is Inhibited by Neomycin in a Ptdlns(4,5)P2-Independent Manner. Cell Biochem. Funct. 2015, 33, 97–100. [Google Scholar] [CrossRef]
- Missiaen, L.; Wuytack, F.; Raeymaekers, L.; De Smedt, H.; Casteels, R. Polyamines and Neomycin Inhibit the Purified Plasma-Membrane Ca2+ Pump by Interacting with Associated Polyphosphoinositides. Biochem. J. 1989, 261, 1055–1058. [Google Scholar] [CrossRef] [PubMed]
- Niemeyer, M.I.; Cid, L.P.; Paulais, M.; Teulon, J.; Sepúlveda, F.V. Phosphatidylinositol (4,5)-Bisphosphate Dynamically Regulates the K2P Background K+ Channel TASK-2. Sci. Rep. 2017, 7, 1–14. [Google Scholar] [CrossRef] [PubMed]
- Zhou, Y.; Wong, C.O.; Cho, K.J.; Van Der Hoeven, D.; Liang, H.; Thakur, D.P.; Luo, J.; Babic, M.; Zinsmaier, K.E.; Zhu, M.X.; et al. Membrane Potential Modulates Plasma Membrane Phospholipid Dynamics and K-Ras Signaling. Science 2015, 349, 873–876. [Google Scholar] [CrossRef]
- Yoshida, S.; Bartolini, S.; Pellman, D. Mechanisms for Concentrating Rho1 during Cytokinesis. Genes Dev. 2009, 23, 810–823. [Google Scholar] [PubMed]
- Audhya, A.; Emr, S.D. Stt4 Pl 4-Kinase Localizes to the Plasma Membrane and Functions in the Pkc1-Mediated MAP Kinase Cascade. Dev. Cell 2002, 2, 593–605. [Google Scholar] [CrossRef]
- Lockshon, D.; Olsen, C.P.; Brett, C.L.; Chertov, A.; Merz, A.J.; Lorenz, D.A.; Van Gilst, M.R.; Kennedy, B.K. Rho Signaling Participates in Membrane Fluidity Homeostasis. PLoS ONE 2012, 7. [Google Scholar] [CrossRef]
- Nunez, L.R.; Jesch, S.A.; Gaspar, M.L.; Almaguer, C.; Villa-Garcia, M.; Ruiz-Noriega, M.; Patton-Vogt, J.; Henry, S.A. Cell Wall Integrity MAPK Pathway Is Essential for Lipid Homeostasis. J. Biol. Chem. 2008, 283, 34204–34217. [Google Scholar] [CrossRef]
- François, B.; Russell, R.J.M.; Murray, J.B.; Aboul-ela, F.; Masquida, B.; Vicens, Q.; Westhof, E. Crystal Structures of Complexes between Aminoglycosides and Decoding A Site Oligonucleotides: Role of the Number of Rings and Positive Charges in the Specific Binding Leading to Miscoding. Nucleic Acids Res. 2005, 33, 5677–5690. [Google Scholar] [CrossRef]
- Pérez-Fernández, D.; Shcherbakov, D.; Matt, T.; Leong, N.C.; Kudyba, I.; Duscha, S.; Boukari, H.; Patak, R.; Dubbaka, S.R.; Lang, K.; et al. 4′-O-Substitutions Determine Selectivity of Aminoglycoside Antibiotics. Nat. Commun. 2014, 5, 3112. [Google Scholar] [CrossRef]
- Fosso, M.Y.; Li, Y.; Garneau-Tsodikova, S. New Trends in Aminoglycosides Use. Medchemcomm 2014, 5, 1075–1091. [Google Scholar] [CrossRef]
- Qian, Y.; Guan, M.X. Interaction of Aminoglycosides with Human Mitochondrial 12S RRNA Carrying the Deafness-Associated Mutation. Antimicrob. Agents Chemother. 2009, 53, 4612–4618. [Google Scholar] [CrossRef] [PubMed]
- Voth, W.P.; Richards, J.D.; Shaw, J.M.; Stillman, D.J. Yeast Vectors for Integration at the HO Locus. Nucleic Acids Res. 2001, 29, 10–13. [Google Scholar] [CrossRef] [PubMed]
- Goldstein, A.L.; McCusker, J.H. Three New Dominant Drug Resistance Cassettes for Gene Disruption in Saccharomyces Cerevisiae. Yeast 1999, 15, 1541–1553. [Google Scholar] [CrossRef]
- Gietz, R.D.; Akio, S. New Yeast-Escherichia Coli Shuttle Vectors Constructed with in Vitro Mutagenized Yeast Genes Lacking Six-Base Pair Restriction Sites. Gene 1988, 74, 527–534. [Google Scholar] [CrossRef]
- Oliver, M.D.; Fernández-Acero, T.; Luna, S.; Rodríguez-Escudero, I.; Molina, M.; Pulido, R.; Cid, V.J. Insights into the Pathological Mechanisms of P85α Mutations Using a Yeast-Based Phosphatidylinositol 3-Kinase Model. Biosci. Rep. 2017, 37, 1–14. [Google Scholar] [CrossRef]
- Martín, H.; Rodríguez-Pachón, J.M.; Ruiz, C.; Nombela, C.; Molina, M. Regulatory Mechanisms for Modulation of Signaling through the Cell Integrity Slt2-Mediated Pathway in Saccharomyces Cerevisiae. J. Biol. Chem. 2000, 275, 1511–1519. [Google Scholar] [CrossRef]
- Han, E.S.; Wu, Y.; McCarter, R.; Nelson, J.F.; Richardson, A.; Hilsenbeck, S.G. Reproducibility, Sources of Variability, Pooling, and Sample Size: Important Considerations for the Design of High-Density Oligonucleotide Array Experiments. J. Gerontol. Ser. A Biol. Sci. Med. Sci. 2004, 59, 306–315. [Google Scholar] [CrossRef]
- Baldi, P.; Long, A.D. A Bayesian Framework for the Analysis of Microarray Expression Data: Regularized t-Test and Statistical Inferences of Gene Changes. Bioinformatics 2001, 17, 509–519. [Google Scholar] [CrossRef]
- Saeed, A.I.; Bhagabati, N.K.; Braisted, J.C.; Liang, W.; Sharov, V.; Howe, E.A.; Li, J.; Thiagarajan, M.; White, J.A.; Quackenbush, J. [9] TM4 Microarray Software Suite. Methods Enzymol. 2006, 411, 134–193. [Google Scholar]
- Saeed, A.I.; Sharov, V.; White, J.; Li, J.; Liang, W.; Bhagabati, N.; Braisted, J.; Klapa, M.; Currier, T.; Thiagarajan, M.; et al. TM4: A Free, Open-Source System for Microarray Data Management and Analysis. Biotechniques 2003, 34, 374–378. [Google Scholar] [CrossRef]
- Livak, K.J.; Schmittgen, T.D. Analysis of Relative Gene Expression Data Using Real-Time Quantitative PCR and the 2−ΔΔCT Method. Methods 2001, 25, 402–408. [Google Scholar] [CrossRef] [PubMed]
- Schuldiner, M.; Collins, S.R.; Thompson, N.J.; Denic, V.; Bhamidipati, A.; Punna, T.; Ihmels, J.; Andrews, B.; Boone, C.; Greenblatt, J.F.; et al. Exploration of the Function and Organization of the Yeast Early Secretory Pathway through an Epistatic Miniarray Profile. Cell 2005, 123, 507–519. [Google Scholar] [CrossRef] [PubMed]
- Gallego, C.; Garí, E.; Colomina, N.; Herrero, E.; Aldea, M. The Cln3 Cyclin Is Down-Regulated by Translational Repression and Degradation during the G1 Arrest Caused by Nitrogen Deprivation in Budding Yeast. EMBO J. 1997, 16, 7196–7206. [Google Scholar] [CrossRef]
- De La Torre-Ruiz, M.A.; Torres, J.; Ariño, J.; Herrero, E. Sit4 Is Required for Proper Modulation of the Biological Functions Mediated by Pkc1 and the Cell Integrity Pathway in Saccharomyces cerevisiae. J. Biol. Chem. 2002, 277, 33468–33476. [Google Scholar] [CrossRef]
- Sikorski, R.S.; Hieter, P. A System of Shuttle Vectors and Yeast Host Strains Designed for Efficient Manipulation of DNA in Saccharomyces cerevisiae. Genetics 1989, 122, 19–27. [Google Scholar] [CrossRef] [PubMed]

Publisher’s Note: MDPI stays neutral with regard to jurisdictional claims in published maps and institutional affiliations. |
© 2022 by the authors. Licensee MDPI, Basel, Switzerland. This article is an open access article distributed under the terms and conditions of the Creative Commons Attribution (CC BY) license (https://creativecommons.org/licenses/by/4.0/).
Share and Cite
Jiménez-Gutiérrez, E.; Fernández-Acero, T.; Alonso-Rodríguez, E.; Molina, M.; Martín, H. Neomycin Interferes with Phosphatidylinositol-4,5-Bisphosphate at the Yeast Plasma Membrane and Activates the Cell Wall Integrity Pathway. Int. J. Mol. Sci. 2022, 23, 11034. https://doi.org/10.3390/ijms231911034
Jiménez-Gutiérrez E, Fernández-Acero T, Alonso-Rodríguez E, Molina M, Martín H. Neomycin Interferes with Phosphatidylinositol-4,5-Bisphosphate at the Yeast Plasma Membrane and Activates the Cell Wall Integrity Pathway. International Journal of Molecular Sciences. 2022; 23(19):11034. https://doi.org/10.3390/ijms231911034
Chicago/Turabian StyleJiménez-Gutiérrez, Elena, Teresa Fernández-Acero, Esmeralda Alonso-Rodríguez, María Molina, and Humberto Martín. 2022. "Neomycin Interferes with Phosphatidylinositol-4,5-Bisphosphate at the Yeast Plasma Membrane and Activates the Cell Wall Integrity Pathway" International Journal of Molecular Sciences 23, no. 19: 11034. https://doi.org/10.3390/ijms231911034
APA StyleJiménez-Gutiérrez, E., Fernández-Acero, T., Alonso-Rodríguez, E., Molina, M., & Martín, H. (2022). Neomycin Interferes with Phosphatidylinositol-4,5-Bisphosphate at the Yeast Plasma Membrane and Activates the Cell Wall Integrity Pathway. International Journal of Molecular Sciences, 23(19), 11034. https://doi.org/10.3390/ijms231911034

